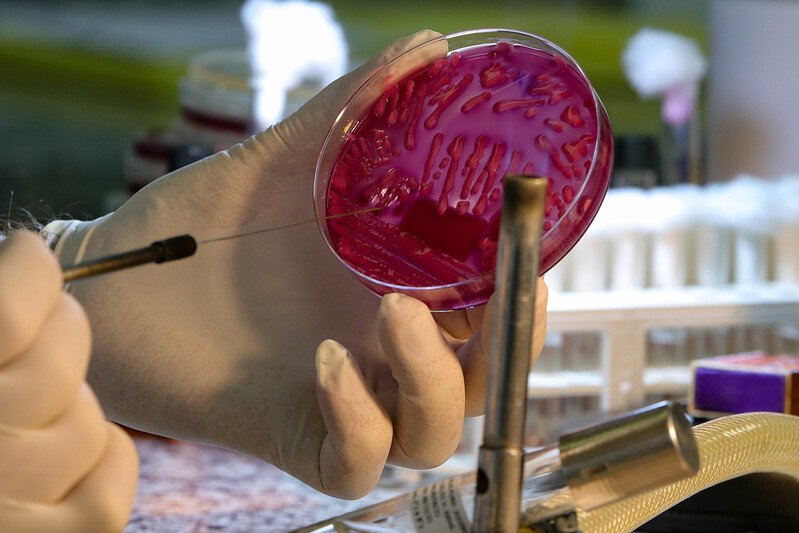

As festas de fim de ano continuam a ter reflexos negativos em relação a disseminação do coronavírus na região.
Em Tubarão, maior cidade da Amurel, a taxa de incidência cresceu 97%, com a confirmação de 139 doentes nesta quarta-feira (5). Os dados referentes a esta quinta-feira (6) ainda não foram divulgados.
Em Braço do Norte, maior cidade do Vale, a quantidade de infectados também é maior. Foram 34 novos casos desta quarta para esta quinta-feira. Um aumento de 50,7%.
Imbituba, um dos maiores destinos turísticos da Amurel, em especial de pessoas de outras regiões do Estado e do país, são 65,4% a mais de casos de Covid confirmados na cidade. Desta quarta para esta quinta, 165 testaram positivo.
Tubarão: a maioria dos doentes são jovens
Conforme dados divulgados pela Fundação Municipal da Saúde de Tubarão, o perfil dos contaminados nestes últimos dias são jovens adultos, com idade entre 20 a 30 anos e que chegam nas unidades de saúde apresentando sintomas como febre, coriza e tosse.
O número de pacientes com comprometimento pulmonar é baixo. A maioria dos pacientes está medicado e faz o tratamento em domicílio, sem necessidade de internação hospitalar.
“Temos a impressão que a população se descuidou um pouco em relação as normas sanitárias. Ainda estamos em pandemia. Nossa orientação continua a mesma: use máscara, não participe de aglomerações, higienize as mãos e não deixe de se vacinar”, pede o diretor-presidente da Fundação, Daisson Trevisol.
Conforme o Notisul publicou mais cedo, a partir desta quinta-feira (06), a vacinação contra a Covid-19 no município será realizada exclusivamente na Arena Multiuso Prefeito Estêner Soratto da Silva, das 9 às 19 horas, de segunda a sexta-feira.
Na Policlínica Central serão aplicadas as demais vacinas existentes, contra outras enfermidades. Nas Unidades Básicas de Saúde, a imunização contra a Covid-19 será aplicada somente por agendamento prévio.
Imbituba: turistas estão entre os mais infectados
Com 417 casos ativos de Covid-19 no município, a preocupação da Secretaria de Saúde da Prefeitura é atender todos que busca, por assistência.
A maior parte dos casos são de turistas que passam férias na cidade. Boa parte dos pacientes apresentam sintomas leves.
Porém, há três pessoas internadas por conta da Covid: dois estão em isolamento (1 confirmado e outro suspeito) e um morador de Garopaba está na Unidade de Terapia Intensiva (UTI) com suspeita da doença.
O Hospital São Camilo registra superlotação desde o fim do ano passado e nas unidades de saúde ainda há filas de pessoas com sintomas gripais.
Braço do Norte: multiplicação dos casos tem ligação com os feriados
Diferente de Tubarão e Imbituba, em Braço do Norte muitos moradores possuem casas de veraneio na região e passaram os feridos de Natal e Ano-Novo na praia.
Com o retorno dos compromissos na cidade, boa parte começou a retornar e com eles, o aumento dos casos. Na maioria dos casos, as pessoas apresentam sintomas leves.
No Hospital Santa Teresinha, a busca por atendimento de pessoas com sintomas respiratórios aumento 271, 31% de dezembro até este início de janeiro. Há uma pessoa internada com suspeita de Covid-19 na instituição.
A partir da próxima segunda-feira (10) o ESF São Francisco de Assis passará a funcionar até as 22 horas, a exemplo do que já ocorre na Policlínica Municipal, para agilizar os atendimentos.
Entre em nosso canal do Telegram e receba informações diárias, inclusive aos finais de semana. Acesse o link e fique por dentro: https://t.me/portalnotisul